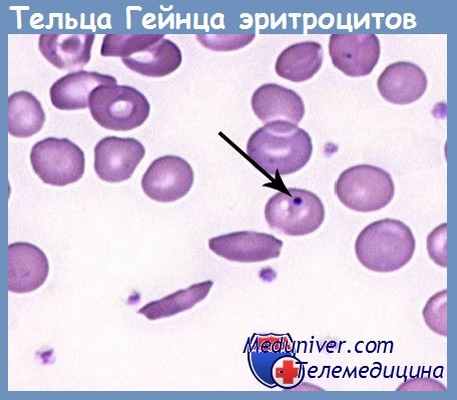
тельца Гейнца эритроцитов

Тельца Гейнца. Образование телец Гейнца
Добавил пользователь Alex Обновлено: 22.11.2025
Тельца Гейнца-Эрлиха
- на анг. яз Heinz-Ehrlich bodies
- на укр. яз Тільця Гейнця-Ерліха
Маркер токсического поражения крови и внутрисосудистого гемолиза.
2. Наименование раздела:
3. Код исследования в прайс-листе :
4. Метод исследования, анализатор:
- Микроскопический метод
Микроскоп "Carl Zeiss Primo Star" (Германия)
6. Вид биоматериала:
7. Вид пробирки/емкости для биоматериала:
8. Описание исследования:
Исследование, направленное на определение эритроцитов с включениями – тельцами Гейнца, являющимися признаком токсического поражения крови и внутрисосудистого гемолиза.
Тельца Гейнца образуются в результате окисления и инактивации тиоловых групп глобина с последующей денатурацией молекулы гемоглобина. Также они могут выявляться у лиц при наследственном дефиците ферментов глюкозо-6-фосфатдегидрогеназы и глутатионредуктазы. Данные тельца представляют собой округлые включения, размером 1-2 мкм, расположенные в цитоплазме эритроцитов по периферии клеток. Они могут быть представлены как единично, так и множественно, очень редко могут быть обнаружены внеклеточно. В норме у здоровых лиц могут быть обнаружены единичные тельца в эритроцитах, иногда они выявляются у новорождённых и у лиц после спленэктомии.
Основными веществами, под воздействием которых в эритроцитах появляются тельца Гейнца, являются окислители гемоглобина. К ним относятся токсичные вещества: анилин и его производные, нитробензол, нитрофенол, фенилгидразин, пиридин, бертолетова соль, тринитротолуол. Они могут попадать в организм человека при контакте с кожей, слизистыми оболочками, при вдыхании паров отравляющих веществ и их соединений. Это актуально для занятых на химическом, химико-фармацевтическом производстве, в специализированных лабораториях. Некоторые лекарственные препараты (нитроглицерин, сульфаниламидные препараты) также могут приводить к образованию включений в эритроцитах. Тельца Гейнца выявляются у пациентов при анемиях, связанных с дефицитом ферментов глюкозо-6-фосфатдегидрогеназы, глутатионредуктазы, при гемолитических анемиях, метгемоглобинемии, некоторых формах талассемий, лучевой болезни.
9. Референсные значения нормы:
10. Показания к назначению:
При подозрении на токсическое поражение крови, при клинических и лабораторных проявлениях гемолиза;
При симптомах отравления токсичными веществами: анилин и его производные, нитробензол, нитрофенол, фенилгидразин, пиридин, бертолетова соль, тринитротолуол и другие;
При симптомах отравления лекарственными препаратами: нитроглицерин, сульфаниламидные препараты и др.;
При клинических проявлениях анемий, связанных с дефицитом ферментов глюкозо-6-фосфатдегидрогеназы, глутатионредуктазы;
При гемолитических анемиях, метгемоглобинемии, талассемии, лучевой болезни.
11. Интерпретация результатов:
интоксикация веществами: анилином, нитробензолом, нитрофенолом, фенилгидразином, пиридином, бертолетовой солью, тринитротолуолом и др.; интоксикация при применении некоторых лекарственных препаратов: нитроглицерин, сульфаниламиды и др.; дефицит ферментов: глюкозо-6-фосфатдегидрогеназы, глутатионредуктазы и др.; гемолитические анемии; метгемоглобинемии; лучевая болезнь; состояние после спленэктомии.
12. Факторы повышения уровня: -
13. Факторы понижения уровня: -
14. Срок выполнения: в течении дня.
15. Правила подготовки:
Общие при сдаче крови (см. правила подготовки к лабораторным исследованиям).
Тельца Гейнца. Образование телец Гейнца
Исследование, направленное на определение эритроцитов с включениями – тельцами Гейнца, являющимися признаком токсического поражения крови и внутрисосудистого гемолиза.
Синонимы русские
Тельца Гейнца; тельца Гейнца-Эрлиха; патологические включения в эритроцитах.
Синонимы английские
Heinz-Ehrlich bodies; pathological inclusions in erythrocytes.
Метод исследования
Какой биоматериал можно использовать для исследования?
Как правильно подготовиться к исследованию?
- Исключить из рациона алкоголь в течение 24 часов до исследования.
- Детям в возрасте до 1 года не принимать пищу в течение 30-40 минут до исследования.
- Не принимать пищу в течение 2-3 часов до исследования, можно пить чистую негазированную воду.
- Исключить физическое и эмоциональное перенапряжение в течение 30 минут до исследования.
- Не курить в течение 30 минут до исследования.
Общая информация об исследовании
В норме при микроскопии окрашенных мазков периферической крови эритроциты не содержат включений и являются бесструктурными. Тельца Гейнца (Гейнца-Эрлиха) относятся к патологическим включениям и могут быть обнаружены при некоторых патологических состояниях.
Тельца Гейнца образуются в результате окисления и инактивации тиоловых групп глобина с последующей денатурацией молекулы гемоглобина. Также они могут выявляться у лиц при наследственном дефиците ферментов глюкозо-6-фосфатдегидрогеназы и глутатионредуктазы. Данные тельца представляют собой округлые включения, размером 1-2 мкм, расположенные в цитоплазме эритроцитов по периферии клеток. Они могут быть представлены как единично, так и множественно, очень редко могут быть обнаружены внеклеточно. В норме у здоровых лиц могут быть обнаружены единичные тельца в эритроцитах, иногда они выявляются у новорождённых и у лиц после спленэктомии.
Основными веществами, под воздействием которых в эритроцитах появляются тельца Гейнца, являются окислители гемоглобина. К ним относятся токсичные вещества: анилин и его производные, нитробензол, нитрофенол, фенилгидразин, пиридин, бертолетова соль, тринитротолуол. Они могут попадать в организм человека при контакте с кожей, слизистыми оболочками, при вдыхании паров отравляющих веществ и их соединений. Это актуально для занятых на химическом, химико-фармацевтическом производстве, в специализированных лабораториях. Некоторые лекарственные препараты (нитроглицерин, сульфаниламидные препараты) также могут приводить к образованию включений в эритроцитах. Тельца Гейнца выявляются у пациентов при анемиях, связанных с дефицитом ферментов глюкозо-6-фосфатдегидрогеназы, глутатионредуктазы, при гемолитических анемиях, метгемоглобинемии, некоторых формах талассемий, лучевой болезни.
Наряду с клинической картиной и данными лабораторных исследований обнаружение телец Гейнца является признаком токсического поражения крови и возникающего внутрисосудистого гемолиза. Отмечается анемический синдром, проявляющийся слабостью, утомляемостью, одышкой, учащением частоты сердечных сокращений. При тяжелом течении могут отмечаться головная боль, повышение температуры тела, рвота, иногда диарея. Признаками гемолитического синдрома являются иктеричность кожи и видимых слизистых оболочек, спленомегалия, поражение почек вплоть до развития тяжелой почечной недостаточности.
Для чего используется исследование?
- Для определения содержания и количества эритроцитов, содержащих тельца Гейнца, в мазке крови при микроскопическом исследовании.
Когда назначается исследование?
- При подозрении на токсическое поражение крови, при клинических и лабораторных проявлениях гемолиза;
- При симптомах отравления токсичными веществами: анилин и его производные, нитробензол, нитрофенол, фенилгидразин, пиридин, бертолетова соль, тринитротолуол и другие;
- При симптомах отравления лекарственными препаратами: нитроглицерин, сульфаниламидные препараты и др.;
- При клинических проявлениях анемий, связанных с дефицитом ферментов глюкозо-6-фосфатдегидрогеназы, глутатионредуктазы;
- При гемолитических анемиях, метгемоглобинемии, талассемии, лучевой болезни.
Что означают результаты?
Референсные значения: 0 - 5 *10^4.
- Интоксикация веществами: анилином, нитробензолом, нитрофенолом, фенилгидразином, пиридином, бертолетовой солью, тринитротолуолом и др.;
- Интоксикация при применении некоторых лекарственных препаратов: нитроглицерин, сульфаниламиды и др.;
- Дефицит ферментов: глюкозо-6-фосфатдегидрогеназы, глутатионредуктазы и др.;
- Гемолитические анемии;
- Метгемоглобинемии;
- Лучевая болезнь;
- Состояние после спленэктомии.
В норме тельца Гейнца не обнаруживаются.
Что может влиять на результат?
- Возраст;
- Занятость на вредных производствах;
- Наличие сопутствующих заболеваний;
- Применение лекарственных препаратов.
Также рекомендуется
4 Общий анализ крови (без лейкоцитарной формулы и СОЭ)
14 Клинический анализ крови: общий анализ, лейкоцитарная формула, СОЭ (с микроскопией мазка крови при выявлении патологических изменений)
Тельца Гейнца. Образование телец Гейнца
Тельца Гейнца. Образование телец Гейнца
В итоге в основе образования телец Геинца лежит окисление или блокада двух реактивных тиоловых групп глобина при условии, что превращение феррогема в ферригем (т.е. переход гемоглобина в метгемоглобин) значительно повышает вероятность окисления тиоловых групп глобина, а следовательно, и денатурированного пигмента.
Окисление, равно как и восстановление уже окисленных тиоловых групп глобина, во многом зависит от восстановленного глютатиона (Г-SH). Последний, помимо защиты тиоловых групп глобина, препятствует инактивации тиоловых ферментов и сульфгидрильных групп мембраны эритроцитов. Недаром Г-SH получил название "тиоловый щит эритроцитов", который поддерживает красящее вещество крови в деятельном состоянии. Как правило, под влиянием веществ-метгемоглобинобразователей запасы Г-SH истощаются, хотя не исключено и увеличение уровня Г-SH, что может рассматриваться как компенсаторная реакция, связанная с усиленной потребностью в нем при восстановлении метгемоглобина. Важную роль в денатурации кровяного пигмента играют также SH-группы мембраны эритроцитов, поскольку они являются первичным диффузным барьером по предотвращению проникновения веществ-окислителей внутрь клеток.
По данным D.Allen, наряду с инактивацией SH-групп мембраны эритроцитов происходит окисление сначала двух реактивных тиоловых групп глобина, а затем и остальных 4 SH-групп, что приводит к денатурации молекулы гемоглобина. Денатурированный гемоглобин связывает молекулы Г-SH, полимеризуется через водородные связи и выпадает в виде телец Гейнца. Размеры последних прямо пропорциональны времени денатурации гемоглобина и количеству молекул Г-SH.
Схематично процесс образования телец Гейнца может быть представлен следующим образом:
1. Окисление гемоглобина в метгемоглобин до равновесного состояния гемоглобин — метгемоглобин.
2. Окисление двух реактивных SH-групп глобина.
3. Окисление оставшихся SH-групп глобина.
4. Денатурация и осаждение пигмента в виде телец Гейнца.
Как правило, эритроциты, содержащие тельца Гейнца, под их влиянием разрушаются, что в итоге приводит к гемолизу с укорочением срока жизни эритроцитов. Однако в данном случае существенную роль играют размеры телец Гейнца. Известно, что при незначительной степени воздействия тех же нитро- и аминосоединений ряда бензола тельца Гейнца остаются мелкими, иногда имея пылевидную форму, сохраняются в эритроците до 3 нед без нарушения их целостности. Однако чаще всего, а при выраженных формах отравления всегда, тельца Гейнца достигают размеров до 1-2 u и более в диаметре, выделяясь из эритроцита уже на 3—4-й день и разрушая его. Но вместе с тем следует отметить удивительную способность селезенки удалять тельца Гейнца из эритроцитов, не разрушая последние. Естественно, что в первую очередь это касается мелких включений. Конечно же, более универсальная реакция — разрушение эритроцитов по выходе телец Гейнца из внутри- во внеклеточное пространство. В результате наряду с падением уровня гемоглобина падает и число эритроцитов, следствием является развитие гемолитической анемии с образованием продуктов распада метгемоглобина, при котором не происходит разрыва порфиринового кольца.
Особенность гемолиза под влиянием метгемоглобинобразователей заключается в том, что он является вторичным. Как следствие острого гемолиза развивается гиперхромная гемолитическая анемия регенераторного типа. Об омоложении красной крови свидетельствуют ретикулоциты, появление нормобластов, телец Жолли, повышение кислотоустойчивости эритроцитов, судя по уплощению кислотных эритрограмм или сдвигу вправо.
Гемолитическая анемия неизбежно приводит к развитию аноксемии и аноксии гемического типа. Как результат этого возможно токсическое влияние на эритропоэз, о чем свидетельствуют такие изменения клеток красной крови, как мегалобластоидия, кариорексис, атипизм митозов нормобластов анизо- и пойкилоцитоз.
Учитывая разную степень проявления мет- и сульфгемоглобинобразующей активности, а также анемизирующего действия амино- и нитропроизводных бензола предложена классификация соединений, принадлежащих к этому классу по степени гемотоксического действия. Она включает 5 градаций с учетом таких критериев, как пиковые значения сульф- и метгемоглобинемии, число телец Гейнца и падение уровня общего гемоглобина и оксигемоглобина. На примере более чем 40 веществ доказано, что более половины из них обладают гемотоксическими свойствами в чрезвычайно сильной или сильной степени по одному или нескольким признакам, хотя встречаются и такие, которые имеют их в слабой степени или даже отмечается полное их отсутствие.
В результате изучения сравнительной гемотоксической активности в стандартных условиях эксперимента убедительно доказано, что выраженной способностью избирательно поражать красную кровь по типу веществ-метгемоглобинобразователей, помимо анилина и нитробензола, обладают алкил- и алкоксипроизводные анилина (все изомеры толуидина, анизидины, р-фенетидин, цианпроизводные этиланилина), хлоранилины, нитрохлорбензолы, динитро- и тринитротолуол, p-нитрофенетол, m-- и p-нитро-о-аминоанизол.
Информация на сайте подлежит консультации лечащим врачом и не заменяет очной консультации с ним.
См. подробнее в пользовательском соглашении.
Анализ эритроцитов на тельца Гейнца-Эрлиха
Для подтверждения ряда диагнозов необходимо обследование крови на выявление в эритроцитах так называемых телец Гейнца-Эрллиха. В Москве такой анализ делают в диагностическом отделе нашей клиники. Лабораторная диагностика у нас проводится с использованием инновационного оборудования, а забор крови проходит быстро и в комфортных для пациента условиях.
Заполните форму, чтобы записаться сейчас
— Важно! Для ряда исследований кровь следует сдавать строго в определенное время суток, в другое время результаты могут быть не информативными. Пожалуйста, посоветуйтесь со своим лечащим врачом.
Синонимы английские и русские
Описание исследования
Методики исследования
Для чего проводится исследование
В каких ситуациях назначается анализ
Кто может назначить анализ
Какой биоматериал используется
Подготовительный этап
Интерпретация результатов
Что влияет на результат исследования
Литература
Синонимы английские и русские
В медицинской литературе анализ может также обозначаться как исследование на тельца Гейнца или на патологические включения (вещества) в эритроцитах. На английском это звучит, как Heinz-Ehrlich bodies, реже встречается термин pathological inclusions in erythrocyte.
Описание исследования
При микроскопическом осмотре окрашенных мазков крови в норме эритроциты должны быть бесструктурными, не содержащими никаких включений. Тельца Гейнца указывают на патологические процессы в организме. Это включения округлой формы размером не более 2 мкм. Расположены они обычно в цитоплазме в периферической части клеток, реже обнаруживаются внеклеточно. Допустимо присутствие в эритроцитах единичных телец, на патологию указывает их повышение более, чем в 4-5 раз. К физиологическим относят тельца Гейнца, обнаруженные в крови у новорожденных, и лиц, перенесших удаление селезенки.
Образование посторонних включений связано с окислением и последующей инактивацией глобина (тиоловых его групп), что приводит к денатурации, то есть к изменению свойств молекул гемоглобина. Реже тельца появляются у лиц с нехваткой таких ферментов, как глютатионредуктаза и глюкозо-6-фосфатдегидрогеназа. Такой дефицит чаще всего обусловлен наследственной предрасположенностью.
К образованию в эритроцитах посторонних включений приводят окислители гемоглобина, это такие токсичные соединения, как:
- Анилин (аминобензол) и все его производные;
- Пиридин;
- Нитрофенольные комплексы;
- Хлорат калия;
- Фенилгидразин.
Перечисленные выше соединения и ряд других ядовитых веществ в организм могут попадать через слизистые оболочки и кожный покров, часть из них имеет летучие комплексы, проникающие в дыхательную систему. Отравление окислителями гемоглобина в основном происходит на химических предприятиях, в специализированных лабораториях, и в компаниях, занимающихся производством фармпрепаратов.
К образованию телец Гейнца приводят и некоторые лекарственные препараты, особенно в тех случаях, если они поступают в организм в увеличенной дозировке. Это относится к сульфаниламидам, нитроглицерину, парацетамолу. Посторонние включения в мазке крови могут быть обнаружены при некоторых типах анемии, при лучевой болезни и талассемии.
При обнаружении в обследуемом образце множественных телец Гейнца и соответствующей клинической картине врач может сделать вывод о токсическом поражении крови и сопутствующем внутрисосудистом гемолизе. Заподозрить эти состояния можно по сильной слабости, тахикардии, рвоте, головной боли, одышке, тахикардии, по признакам почечной недостаточности. Данные состояния требуют немедленного комплексного лечения.
Методики исследования
Для обнаружения посторонних включений в эритроцитах используется микроскопический метод, то есть мазок окрашивается и оценивается под микроскопом.
Для чего проводится исследование
Анализ на тельца Гейнца-Эрллиха позволяют исключить или наоборот подтвердить предполагаемый диагноз. А это в свою очередь необходимо для правильного выбора тактики ведения больного.
В каких ситуациях назначается анализ
Исследование крови на наличие в эритроцитах телец Эрллиха врачи назначают в нескольких случаях:
- Если есть данные за токсическую интоксикацию. Обычно на это указывает гемолиз, подтвержденный соответствующими анализами;
- Если у пациента выявляются симптомы, указывающие на возможное поражение токсичными соединениями и сильными ядами. Особенно внимательно необходимо относиться к пациентам, работа которых связана с контактом с окислителями гемоглобина;
- При явных признаках отравления медикаментами;
- При подозрении на анемию, вызванную дефицитом ферментов;
- Пациентам с талассемией, лучевой болезнью, метгемоглобинемией и анемией гемолитического типа.
В платных клиниках исследование всегда можно пройти без направления от врача.
Кто может назначить анализ
Какой биоматериал используется
Образец для исследования эритроцитов готовится из венозной крови. Берут ее обычно с локтевой вены.
Подготовительный этап
Чтобы не получить недостоверный результат исследования, нужно соблюдать следующие рекомендации:
- Из рациона алкогольные напитки полностью убираются минимум з 24 часа до забора крови;
- До сдачи анализа нужно есть не позднее чем за 4 часа. Негазированную чистую воду пить не запрещено;
- В течение как минимум 30 минут до забора крови нужно постараться не волноваться и избежать психоэмоционального и физического перенапряжения. Этот же промежуток времени не рекомендуется курить.
У маленьких детей кровь желательно брать перед очередным приемом пищи или как минимум через час после еды.
Интерпретация результатов
Расшифровка полученного на руки бланка с результатом анализа проводится только врачом. Определение единичных телец Гейнца не обязательно указывает на токсическое поражение или на тяжелое заболевание. Врач оценивает исследование в совокупности с другими показателями крови. Диагноз также должен быть подтвержден и инструментальными методами. Комплексная диагностика позволит подобрать наиболее эффективную терапию.
Что влияет на результат исследования
Отклонение от нормы в анализах крови может быть связано с возрастом пациента, с несоблюдением им рекомендации по подготовки, с работой во вредных цехах. Тельца Гейнца могут быть обнаружены и на фоне длительной лекарственной терапии рядом препаратов и у пациентов с сопутствующими патологиями.
Тельца Хайнца
Тельца Хайнца (также известные как тельца Гейнца или Гейнца-Эрлиха) - это преципитаты окисленного гемоглобина в эритроците, при окрасках по Романовскому выглядящие как эозинофильные сферические включения, часто выступающие за границы эритроцита. Это достаточно распространенный маркер окислительного повреждения гемоглобина, часто, хотя и необязательно сопутствующий эксцентроцитам и метгемоглобинемии.
Тельца Хайнца (также известные как тельца Гейнца или Гейнца-Эрлиха) - это преципитаты окисленного гемоглобина в эритроците, при окрасках по Романовскому выглядящие как эозинофильные сферические включения, часто выступающие за границы эритроцита. Это достаточно распространенный маркер окислительного повреждения гемоглобина, часто, хотя и необязательно сопутствующий эксцентроцитам и метгемоглобинемии. Наиболее часто тельца Хайнца можно увидеть у кошек, и это связано с некоторыми особенностями их физиологии. Во-первых, в отличие от большинства других видов, у кошек в молекуле гемоглобина есть шесть нестабильных сульфгидрильных групп, и их гемоглобин очень легко диссоциирует из тетрамера в димер. Во-вторых, их несинусоидальная селезенка крайне неэффективна в вопросах удаления включений с поверхности эритроцитов - поэтому, как и в случае с тельцами Хауэлла-Джолли, до 5% эритроцитов с тельцами Хайнца для кошки считается вариантом нормы. Ну и наконец, отсутствие некоторых ферментативных систем не позволяет им эффективно метаболизировать некоторые ксенобиотики, продукты промежуточного обмена которых часто и вызывают образование телец Хайнца. В течение некоторого времени эритроцит может смещать образовавшееся тельце Хайнца к периферии по механизму, аналогичному выталкиванию телец Хауэлла-Джолли, и даже иногда избавляться от него, но чаще всего он не успевает это сделать. Тельце Хайнца само по себе изменяет реологические свойства эритроцита, он становится более хрупким, и в среднем продолжительность жизни эритроцитов резко сокращается. У кошек, поскольку селезенка тельца Хайнца не убирает, основным механизмом элиминации пораженных эритроцитов является гемолиз. В мазках часто можно наблюдать "призраки" эритроцитов - то есть, пустые мембраны без гемоглобина, - с ярко заметным тельцем Хайнца. На фотографии выше такие тоже есть. К распространенным причинам окислительного повреждения эритроцитов относятся: - применение парацетамола. К нему чувствительны опять же особенно кошки, но и у собак распространена гемолитическая реакция. - отравление луком, чесноком. Это, конечно, касается преимущественно собак - заточить лука из-под шашлыков они всегда горазды, а вот кошек, трескающих подобные гадости, увидеть можно редко. - пропиленгликоль у кошек. Раньше часто входил во влажные рационы, сейчас FDA не рекомендовала его применение в кошачьих кормах. Человек к пропиленгликолю чувствителен чуть менее чем никак, поэтому в человеческой еде его полно (любителям покормить со стола на заметку). - любые системные заболевания, сопровождающиеся ацидозом. В моей личной тройке лидеров - диабет, особенно с кетоацидозом, септические плевриты, сопровождающиеся пиотораксом и дыхательной недостаточностью, и липидоз. - отравление сильными окислителями (в основном тоже собачья тема): витамин К, антагонисты витамина К, цинк и многое другое. Появление телец Хайнца далеко не всегда сопровождается клинически обнаружимой гемолитической анемией. При умеренной интенсивности поражения костный мозг обычно успевает ответить повышением эритропоэза, и в крови помимо них обнаруживается еще умеренная полихромазия.
Читайте также:
